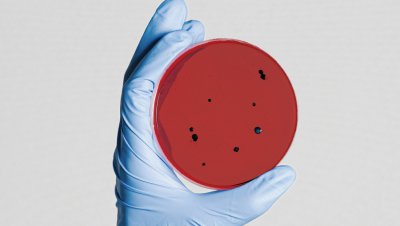

Workshop Data Science, Health Data and AI - 30 September 2020
On September 30th, Datacraft, AP-HP and SCAI organized a workshop on "Data Science, Health Data and AI" to initiate a collaborative program about health data, in order to:
- Contribute to a better knowledge and promotion of the Health Data Warehouse to a wide audience (health and non-health researchers, companies, startups, students, and all sectors combined)
- Set up and animate a dynamic of collaboration, exchange of best practices in terms of data science and research around AP-HP data.
Throughout the academic year 2020/2021, monthly workshops will be organized about:
- data preparation, data quality, data fairification methods
- learning about noisy data
- imaging
- data access procedures, how to make access more fluid.
You can find the presentation and the recording of this online workshop on Datacraft's website (see the link on the left).